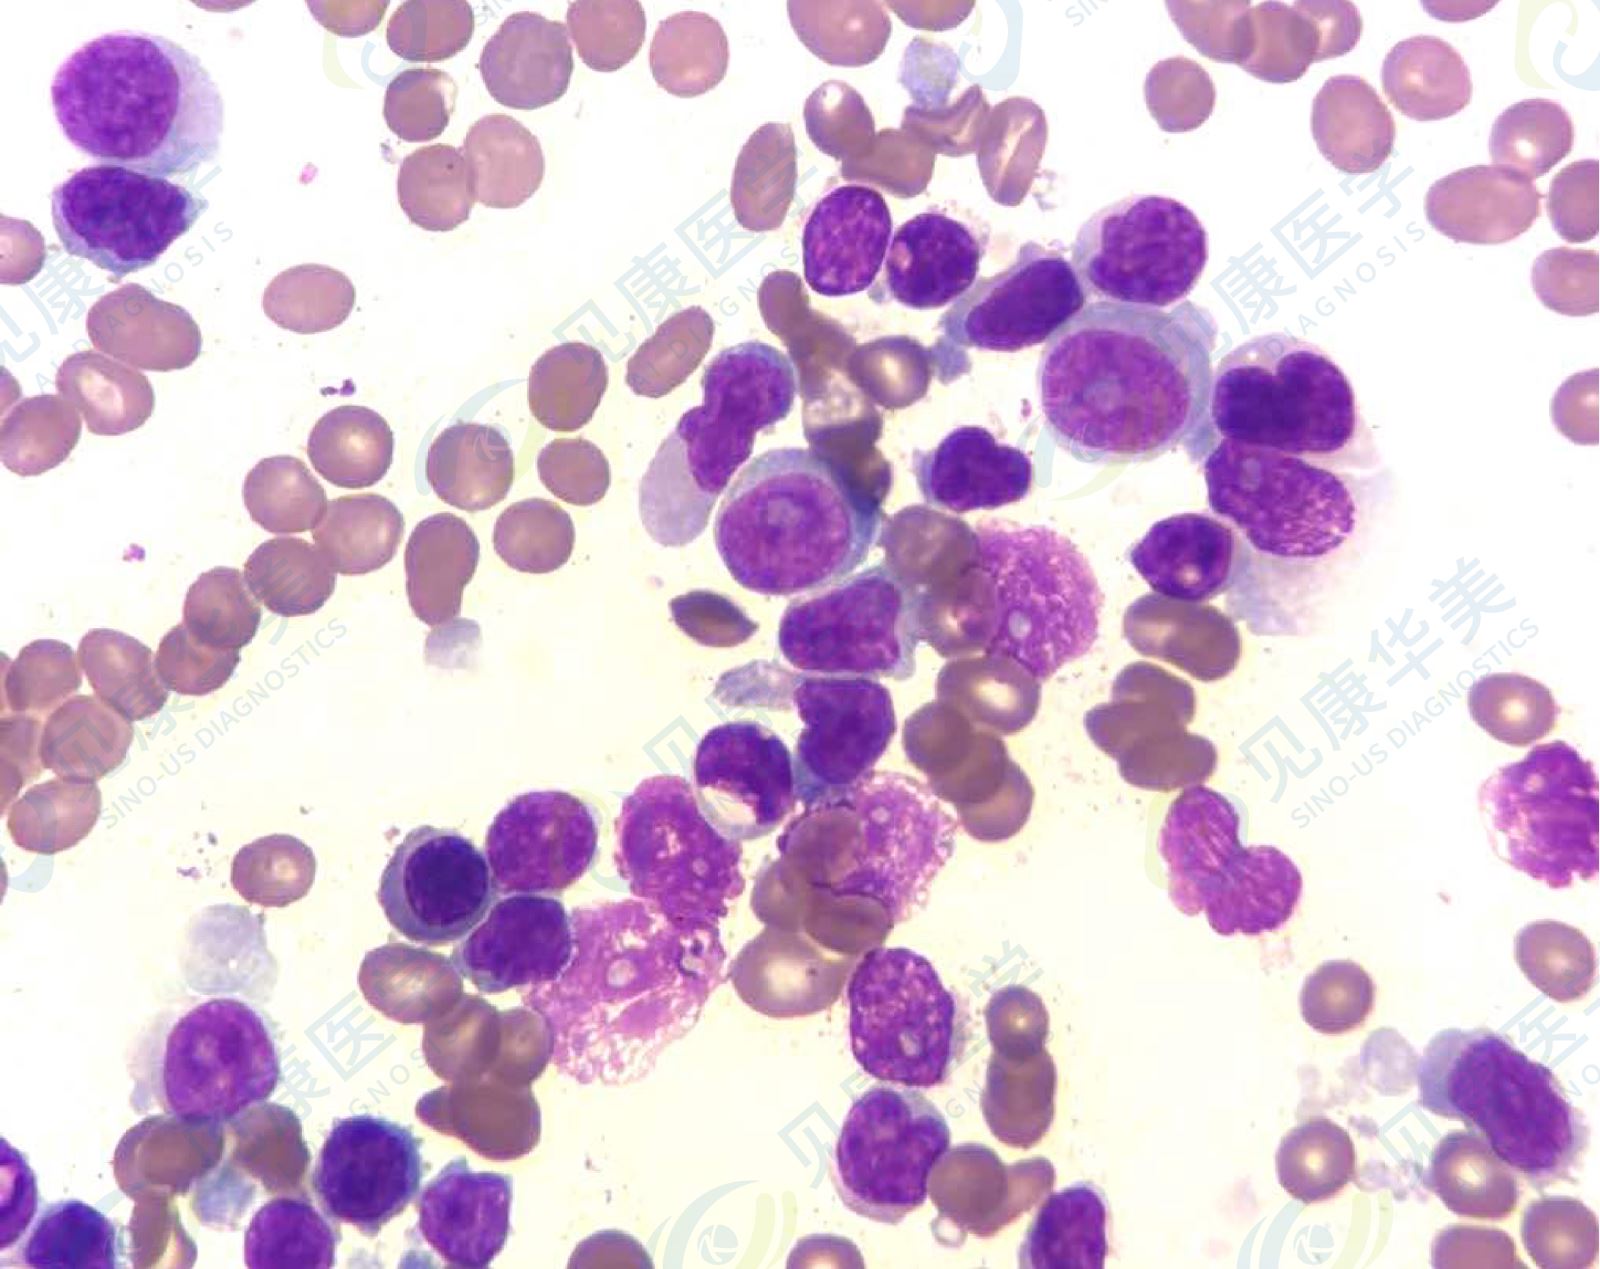
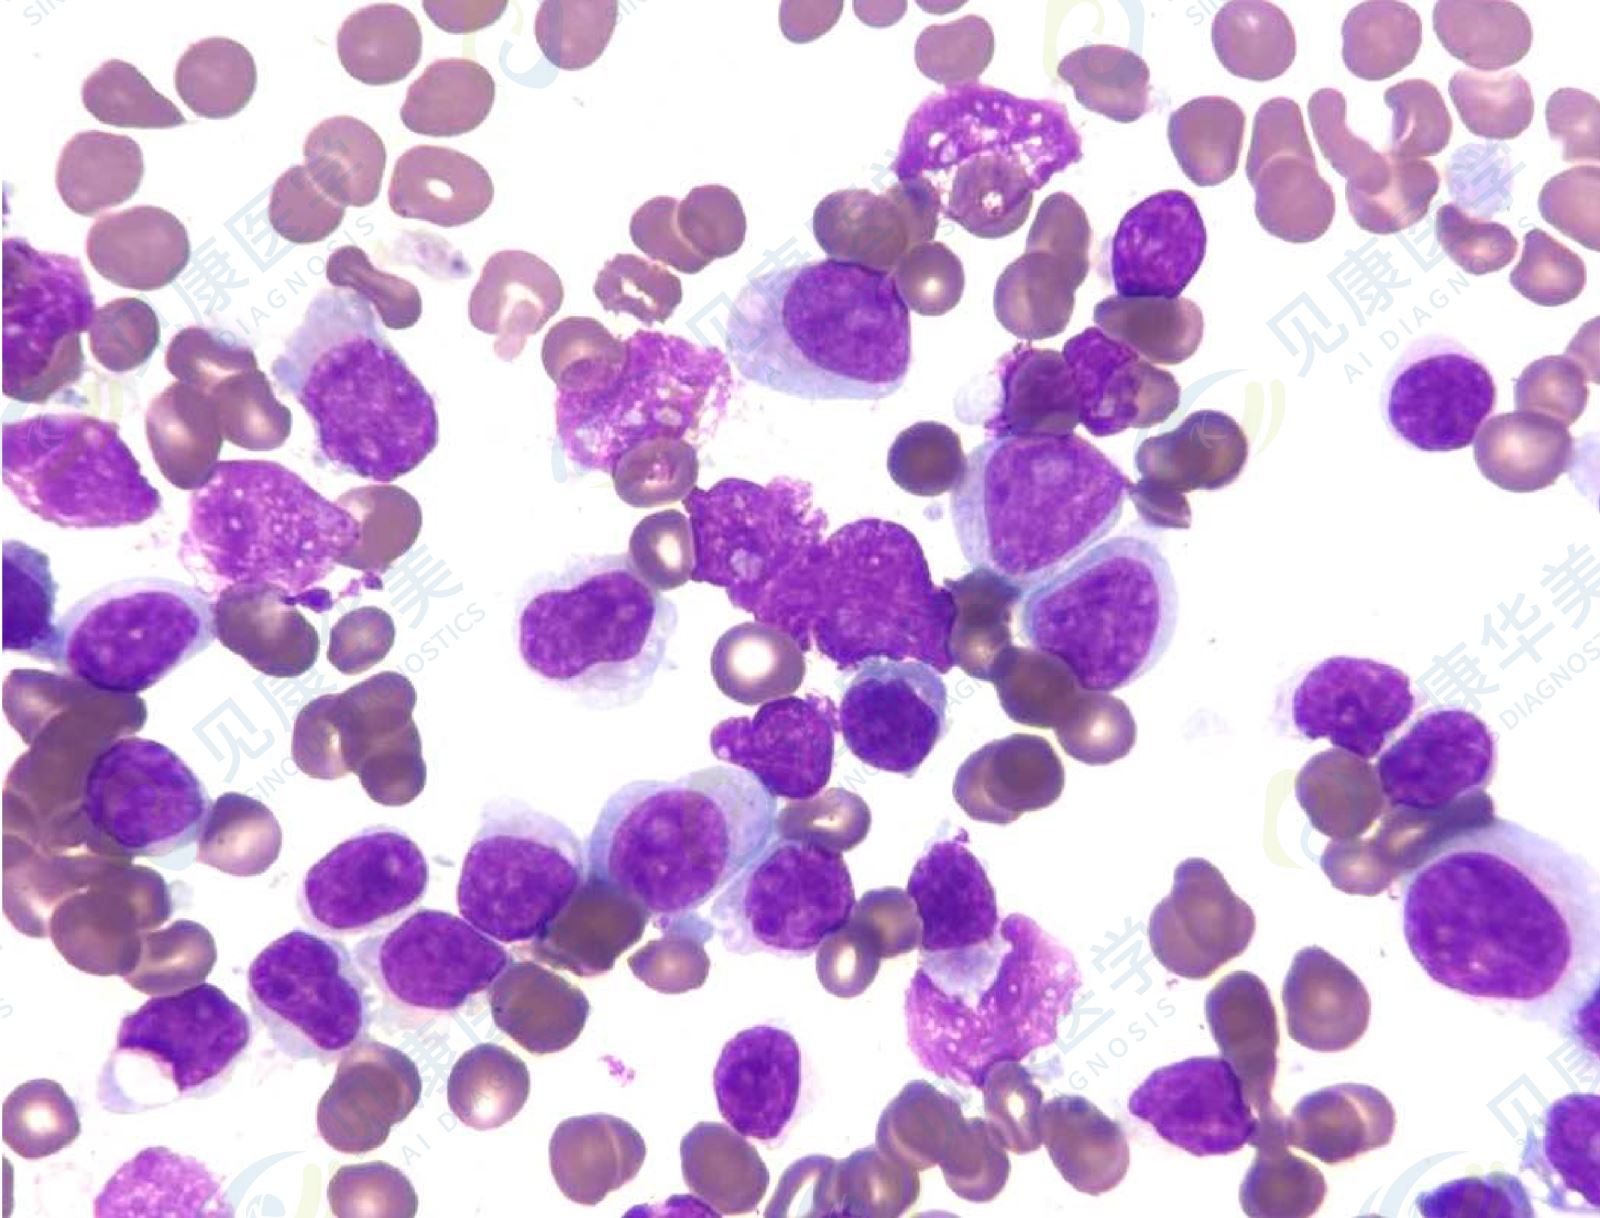

【形态学病例分享】第一百二十五期
患者基本信息:
男,63岁,CLL病史2年。
血常规:
WBC 10.81×109 /L
HB 70 g/L
PLT 21×109 /L
骨髓涂片

病 理

诊断结果
CLL复查,伴幼淋样细胞增多。(WHO 5th 取消PLL,规定CLL病史,外周血具有嗜碱性胞质核和显著核仁的中等大小的成熟淋巴细胞超过15%,考虑疾病进展)
(WHO 5th 取消PLL,规定CLL病史,外周血具有嗜碱性胞质核和显著核仁的中等大小的成熟淋巴细胞超过15%,考虑疾病进展)
CLL复查,伴幼淋样细胞增多。
(WHO 5th 取消PLL,规定CLL病史,外周血具有嗜碱性胞质核和显著核仁的中等大小的成熟淋巴细胞超过15%,考虑疾病进展)